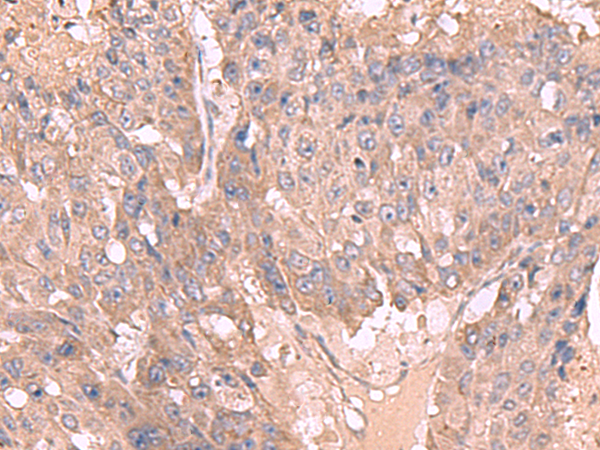
一抗

中文名稱: 兔抗MAGEC2多克隆抗體
英文名稱:Anti-MAGEC2 rabbit polyclonal antibody
別 名: MAGE family member C2; CT10; HCA587; MAGEE1
相關類別:一抗
儲 存: 冷凍(-20℃)
宿 主: Rabbit
抗 原: MAGEC2
反應種屬:Human
標 記 物:Unconjugate
克隆類型:rabbit polyclonal
技術規(guī)格
Background:
This gene is a member of the MAGEC gene family. It is not expressed in normal tissues, except for testis, and is expressed in tumors of various histological types. This gene and the other MAGEC genes are clustered on chromosome Xq26-q27.
Applications:
ELISA, WB, IHC
Name of antibody:
MAGEC2
Immunogen:
Fusion protein of human MAGEC2
Full name:
MAGE family member C2
Synonyms:
CT10; HCA587; MAGEE1
SwissProt:
Q9UBF1
ELISA Recommended dilution:
5000-10000
IHC positive control:
Human cervical cancer and Human colorectal cancer
IHC Recommend dilution:
50-300
WB Predicted band size:
41 kDa
WB Positive control:
293T and Jurkat cell lysates
WB Recommended dilution:
1000-5000


 購物車
購物車 幫助
幫助
 021-54845833/15800441009
021-54845833/15800441009